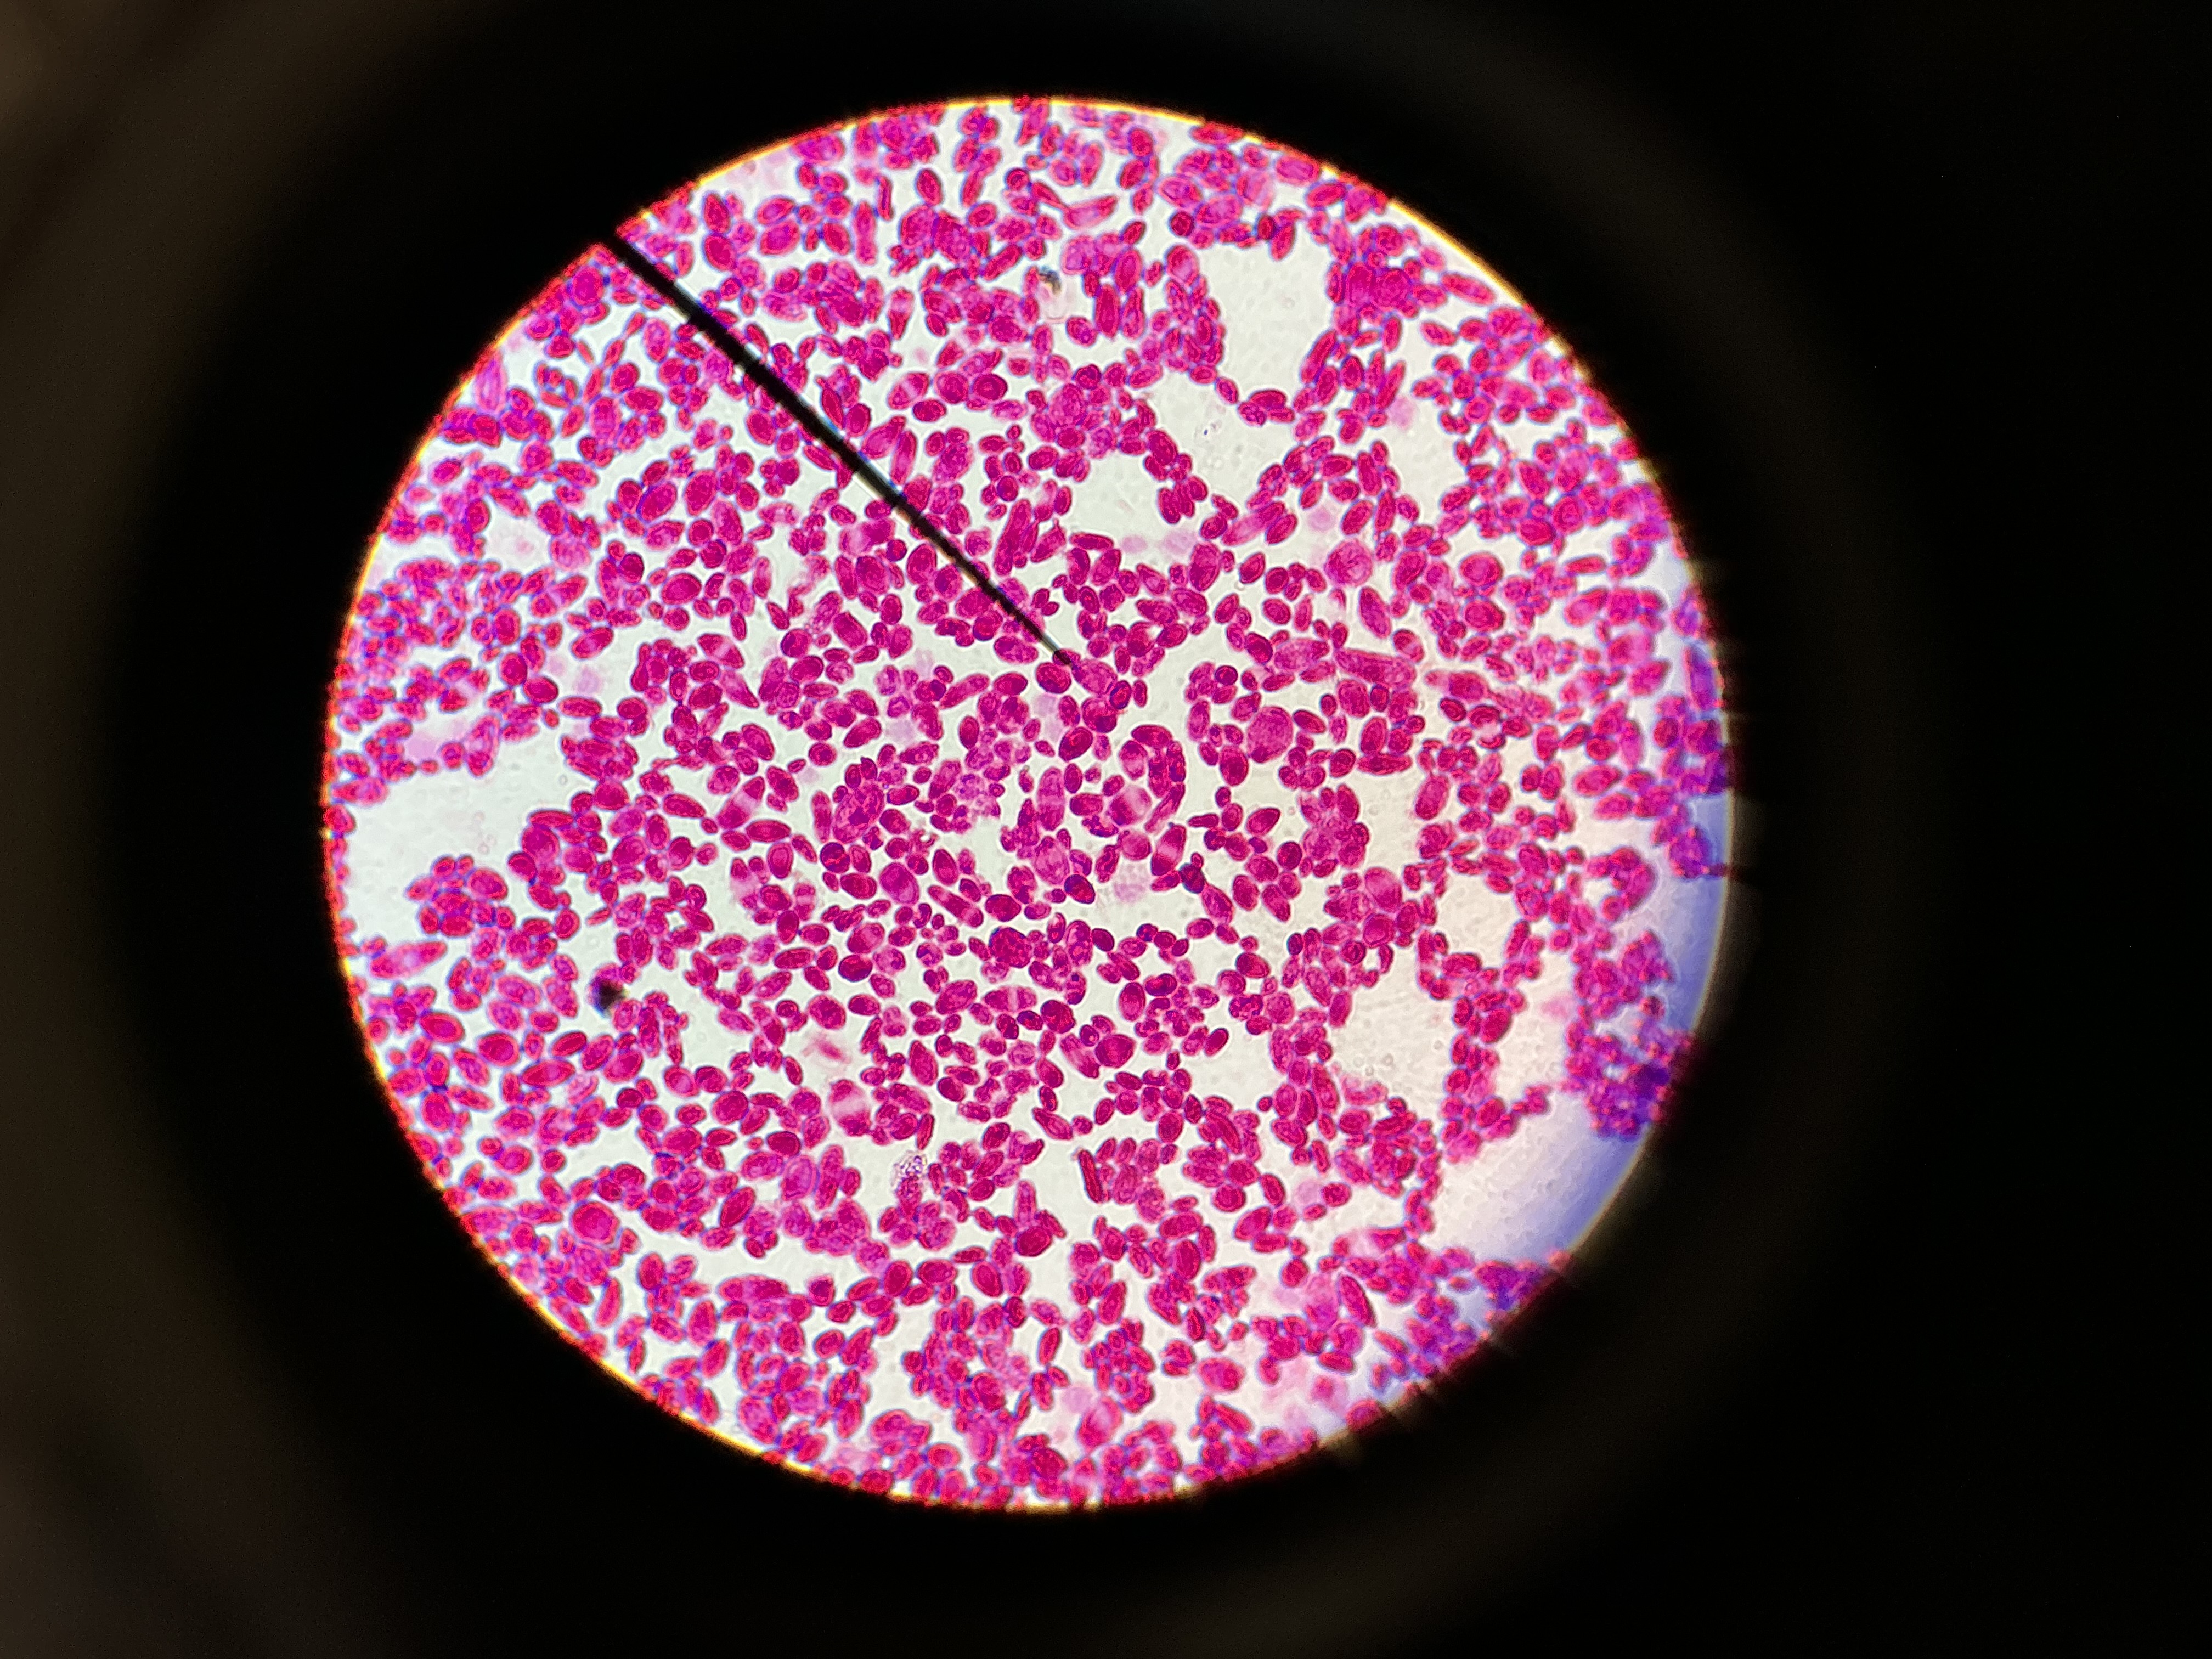

1/19
Looks like no tags are added yet.
Name | Mastery | Learn | Test | Matching | Spaced |
|---|
No study sessions yet.

Balantidium coli (cyst)
Protozoa

Giardia lamblia (intestinalis) cyst
Protozoa

Giardia lamblia (intestinalis) trophozoite
Protozoa

Trypanosoma gambiense
Protozoa

Trichomonas vaginalis
Protozoa

Plasmodium sp.
Protozoa

Taenia allium
Helminths

Schistosoma mansoni
Helminths

Enterobius vermicularis (egg)
Helminths


Diphyllobothrium latum
Helminths

Dirofilaria immitis
Helminths
Candida albicans
Fungi

Trichophyton mentagrophytes
Fungi

S. pyogenes
Bacteria

S. pneumoniae
Bacteria

S. aureus
Bacteria

S. epi
Bacteria

N. gonorrhoea
Bacteria

GC smear (positive)
Bacteria

T. pallidum
Bacteria